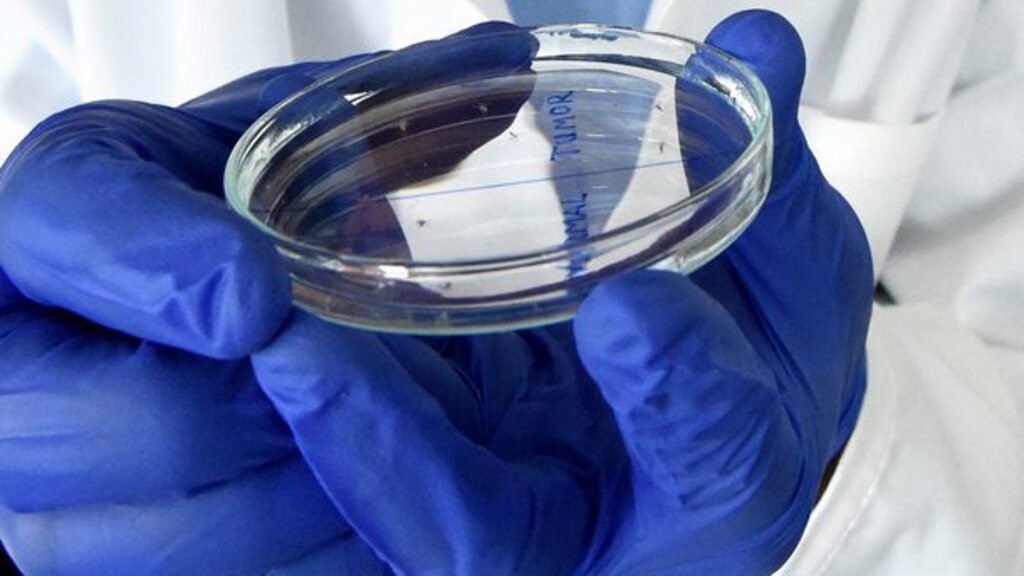

Автор:
Гергана Хрисчева
Интервю
Съвременна имунотерапия и достиженията на медицината за унищожаване на туморните клетки
Как науката разпознава рака днес?
Онкоимунолог и инфекционист са гости в този епизод в подкаста на БНР "В центъра на системата" по темата за онколитичната вирусна терапия
вторник 22 октомври 2024 05:00
вторник, 22 октомври 2024, 05:00

Размер на шрифта
Този епизод на подкаста на БНР - "В центъра на системата" е посветен на търсенията на науката на нови начини за лечение на рак.
Какво е таргетно атакуване и разпознаване чрез вируси и антитела на туморните клетки?
Как онколитичната вирусна терапия може да промени и да направи тумора видим?
Темата беше част от програмата на 23-тата национална среща на фондация "Медии Общество Семейство Традиции" (МОСТ) на тема - "Географски неуравновесеното медицинско обслужване – проблеми и прогнози".
Гости в епизода са:🧫Д-р Георги Димитров - онкоимунолог в Клиниката по медицинска онкология на УМБАЛ "Царица Йоанна - ИСУЛ"
🧫Доц. Трифон Вълков - инфекционист от Инфекциозна болница в София - Катедра по инфекциозни болести към МУ София

От разговора ще научите:
🧫 Къде е науката в модерните начини за борба с рака
🧫 Кои от откритията за диагностика и лечение на рак се прилагат в България
🧫 Как с модифицирани вируси и антитела се борят туморните клетки
🧫 Защо тези модерни терапии са по-ефективни
🧫 Нов стълб в онкологията, генетиката и генното инженерство за диагностика и терапия на злокачествени заболявания
🧫 Взаимодействие между имунотерапията и онколитичната вирусна терапия
🧫 Как се прилагат тези нови терапии у нас и по света
🧫 Какво е бъдещето на онкологията
"Последните 20-30 години онкологията е в своя възход и целта е персонализирана и прецизна онкология за всички пациенти спрямо биологичния характер на определения тумор, каза в подкаста на БНР "В центъра на системата" д-р Георги Димитров.
"Преди основният метод за системно лечение е бил химиотерапията, като в някои случаи и сега тя е най-ефективният метод, като целта й е да унищожи бързоделящи се клетки, каквито са туморните клетки, но тя не щади и нормалните клетки, които се делят бързо. Затова и се наблюдават страничните ефекти при химиотерапията.
Последните години обаче се работи с прицелно лечение, с имунотерапия, с комбинацията между двете и комбинацията и с химиотерапията, и може би най-новата вълна - т.нар. конюгатни медикаменти.
Това са антитела, с прикрепени към тях няколко молекули химиотерапевтик, което прави доставянето на този химиотерапевтик още по-прецизно. Защото той влиза основно в туморната клетка, с много малко, което отива в страничната тъкан и страничните ефекти са много малко, поясни онкоимунологът.
"Аз не съм онколог и не мога да опиша по този начин като д-р Димитров тенденциите, свързани с разработването на нови стратегии по отношение диагностика и терапия на злокачествените заболявания. Но когато говорим за новости и за търсения в тази насока, няма как да не отбележим нещо, което е известно на науката - това е възможността за използването на вируси не само за терапия, но и за диагностика на злокачествените заболявания, коментира доц. Трифон Вълков в подкаста на БНР "В центъра на системата".
"Нещо повече - между самите онколози вече се говори за отделен стълб, свързан с терапията на онкологичните заболявания чрез вируси.
Вируси, които с нашите възможности, защото говорим за комбиниране на няколко фундаментални науки - генетика, вирусология и генното инженерство, даде възможност на вируси, познати на човечеството отдавна, по такъв начин да бъдат модифицирани, да бъдат променени, че те да загубят своите патогенни свойства върху нашия организъм и таргетно да атакуват този тип клетки, които са в основата на туморното заболяване, самата туморна тъкан. Това е пример за таргетна терапия.
Този таргет може да бъде постигнат не само с вирусни клетки, но и с антитела, които също са пример за такъв тип терапия. Те също таргетират определени клетки. Идеята каква е - идеята е тези клетки, които съставляват, които образуват тумора, да бъдат разпознати и само те да бъдат атакувани.
Това, което отличава вирусите като патогенна частица е именно способността да разпознават отделни клетки в състава на една и съща тъкан. И това нещо ние можем да го използваме именно с тази му възможност на вируса да разпознава и да атакува тези клетки.
Те се разделят най-общо на три големи групи - това са т. нар. онколитични вируси, немодифицирани, които по принцип притежават възможността, такъв ефект упражняват - атакувайки съответната тъкан, да предизвикат лизис - разрушаване на клетката, в която навлязат.
Вирусите, които се използват в тази насока са херпесната група вируси, морбили, грип, аденовируси, още други, които са в стадий на доразработване и изследване.
Те както казах, се делят на три групи - такива каквито имат първичен такъв ефект, тоест не се налага да бъдат модифицирани, те навлизат в клетката, разпознават и унищожават.
Другата голяма група са такива, каквито биват модифицирани, благодарение на генното инженерство. Те водят до съвсем друг ефекти - идеята при тях е по такъв начин да повлияят на туморната тъкан, че да я направят видима за имунната система. И самата имунна система да е тази, която ще разпознае и атакува туморите.
Третата група са такива вируси, които дават възможност, те не предизвикват лизис на клетката, но водят до промени в микросредата около самия тумор (който представлява изключително мощна хипоимунна среда - тоест имунният отговор вътре е почти нулев), което е една толерантна среда по отношение на имунната среда за туморната тъкан, тя се развива, без да бъде притеснявана от възможността тя да бъде разпозната и атакувана от имунната система.
Това нещо също е обект, таргет на такъв вид терапия с потискане, с неутрализиране на тоя тип туморна микросреда, и създаване на нещо, което бих казал е уникално по отношение на този тип терапия - създаване на един първичен, активен, антитуморен имунен отговор, поясни още доц. Трифон Вълков.

"Прицелното лечение се прилага вече рутинно, то се оптимизира и развива. Това, за което доц. Вълков говори - онколитичната вирусна терапия - тя предстои тепърва. Това е бъдещото на онкоологичното лечение. С тези три стълба на този вид лечение - директния и индиректния начин за унищожаване на тумора.
Тоест - дали вирусът ще може да се размножава само в определените туморни клетки - модифицирани или с естествен вид. Ние знаем кои вируси имат тропизъм към кои определени туморни клетки - при рака на гърдата и при рака на маточната шийка са различни. Различни вируси имат тропизъм към точно тези различни локализации.
Другото нещо - индиректният начин дали чрез разкриване на антигени, които имунната система не ги е виждала първоначално или чрез модифициране на туморната микросреда. Която е в момента много актуална тема за "разузнаване", чрез различни механизми, включително и чрез промяна микробиома на тумора. Защото епителните тумори, карциномите, които произлизат от кухи органи, примерно на червата, на дихателните пътища, като рака на белия дроб имат микросреда, която те развиват като микроорганизми.
Промяната на това може да доведе до съвсем различно поведение на тумора и съвсем различно поведение на имунната система спрямо тумора.
Онколитичната вирусна терапия може да промени и да направи този тумор видим.
Хитът, който имунотерапията от последните може би 10 години, още от меланома, всички сте чували за т.нар. инхибитори на имунната контролна точка - това е когато, туморите резистират имунния отговор, тоест те го спират чрез "едни спирачки" да разпознават имунните клетки и да ги толерират.
Ние като лекари онколози имаме възможност да дадем антитела, които "стопират тези спирачки", махат ги и имунната система почва да ги вижда.
Обаче не винаги е така, не във всеки тумор и не може да предскажем със сигурност кой тумор ще реагира напълно към имунотерапията и какъв ще е отговорът.
Добавяйки и онколитичната вирусна терапия, поне теоретично към момента вървят проучвания, още са междинни резултатите, обаче са обещаващи, може да допълним този отговор и да постигнем изцяло унищожаване на тумори само със системно лечение, изтъква онкоимунологът д-р Георги Димитров от болница ИСУЛ.
Специалистите обясняват, че за всички видове рак може да се търси и да се създават вируси за атакуване на туморите, припомнят как през 90- те години се е наблюдавало при пациенти с вирусни инфекции да имат известно забавяне на развитието на раковото заболяване, съобщават какво още прави науката сега, за да превърне тези обикновени вируси в мултимодални терапевтични системи, които дават възможност за таргетно атакуване на туморните заболявания, но и нещо повече - да могат да търсят толкова малки следи на рака за ранна диагностика, в които туморът не е видим дори от скенер, ЯМР или ПЕТ- скенер.
Лекарите поясняват за методиката на тропизма, при която модифицирани вируси, носещи маркирани вещества и захващайки се върху такива клетки, изпращат сигнали чрез радиоизотопи къде са туморите. Посочват и къде е България, държавите от Западна Европа и САЩ в използването на онколитичните вирусна терапия в битката с туморите, както и какви други терапии се проучват и на каква фаза са до момента.
Д-р Георги Димитров е завършил медицина от МУ-София със “ Златен Хипократ”. Притежава Бакалавър по Генетика и генно инженерство от University Of Leeds, UK, както и магистърска степен по “Translational oncology” от Imperial College London, UK където прилага протоколите за разработване на нови противотуморни лекарства по програмата от „Лабораторията в практиката“. Д-р Димитров е първи автор на националния интерактивен Справочника за лечение на COVID в България, има сертификат за компетентност в диагностиката и лечението на COVID - 19 от Stanford University, USA .Заедно с д-р Трифон Вълков и д-р Димитров старши са националните координатори за COVID-19. Той е и сред отличените с престижното отличие на БЛС в категорията „Ти си нашето бъдеще“ за 2021г. Съавтор е на множество публикации в Български и международни списания обхващащи различни аспекти на онкологията и COVID-19, както и активни участия на национални и международни форуми.
Доц. Трифон Вълков (MD, PhD) е специалист по Инфекциозни болести. Завършва медицина през 2013г. (Медицински университет, София). Работи последователно в отделение по въздушно-капкови, покривни, трансмисивни и невроинфекции и в отделението за лечение на пациенти с COVID-19 към СБАЛИПБ – „Проф. Ив. Киров“ ЕАД София, от началото на пандемията. В моментa е главен асистент по Инфекциозни болести към същата катедра (МУ-София). Придобива специалност по Инфекциозни болести (2018г.) и ОНС „ДОКТОР“ по Инфекциозни болести (2018г.). Член на Българското дружество по Инфекциозни болести. Научните му интереси са в областта на Клиничната вирусология и остри инфекции на ЦНС с вирусна и бактериална етиология.
Очаквам вашите сигнали, коментари и предложения на имейл: gergana.hrischeva@bnr.bg
Всички епизоди на подкаста ще намерите:
Apple Podcasts през iTunes
По публикацията работи: Гергана Хрисчева
Последвайте ни и в Google News Showcase, за да научите най-важното от деня!
